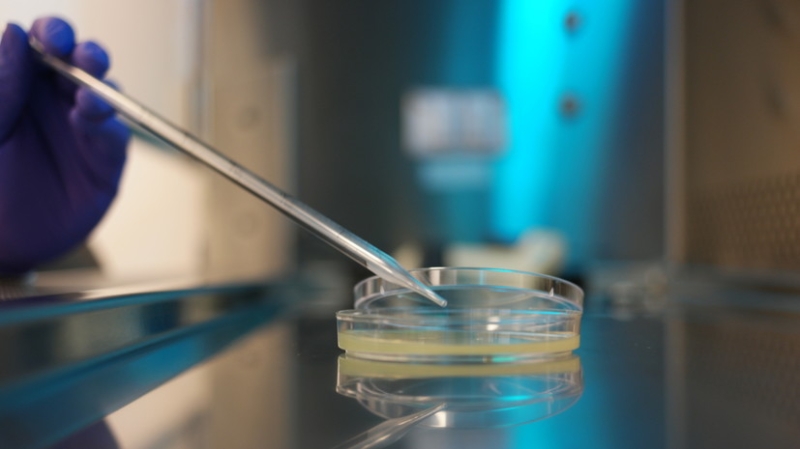
Роспотребнадзор расследует отравление 31 сотрудника мясокомбината в Москве

Роспотребнадзор расследует отравление 31 сотрудника Черкизовского мясокомбината в Москве.
Об этом сообщает ведомство.
В стационары Москвы госпитализирован 31 сотрудник предприятия с острой кишечной инфекцией.
«Все пострадавшие употребляли в пищу обеденные блюда в закрытой столовой для сотрудников организатора питания ООО «СС Ресторанс энд кафе», — говорится в сообщении.
Уточняется, что в ходе расследования отобраны «суточные пробы готовых пищевых продуктов, сырья, воды, смывы с поверхностей окружающей среды, рук и одежды персонала», а также изъяты 793 кг пищевой продукции.
Ситуация находится на особом контроле Роспотребнадзора. Кафе временно закрыто, предприятие опечатано.
Ранее сообщалось, что в Дагестане возбуждено уголовное дело по факту отравления водой 18 жителей села Эрпели Буйнакского района.











